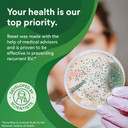
Good Clean Love Reset Homeopathic Vaginal Suppository, Bacterial Vaginosis Treatment For Women, Relieves Itching & Irritation, Feminine Care, Promotes Urinary Tract & Vaginal Health, 10 Capsules

Package Dimensions :1.75 x 3.13 x 5.13 inches 1.13 ounces
Imported By : Esupli
Manufacture : Good Clean Love
About this item ACCESSIBLE OVER-THE -COUNTER RELIEF: The first vaginal suppository of its kind, Reset provides affordable and easily accessible relief and bacterial vaginosis treatment. Helps relieve itching, irritation, vaginal odors, and abnormal discharge WORKS WHILE YOU SLEEP: Each Reset capsule is inserted vaginally rather than swallowed, dissolves easily, and works while you sleep. Regular use of Reset, along with good hygiene, helps you maintain vaginal health and find relief from BV symptoms EASY TO USE FEMININE CARE: Each pack contains 10 suppository gel capsules and a reusable, easy-to-clean applicator. Use every 3 days for up to 7 days, or as instructed by a doctor, to help reduce BV symptoms. Reset helps promote urinary tract health HELPS MAINTAIN VAGINAL HEALTH: A healthy vaginal biome has a low pH and a proper balance of moisture, salt, and lactic acid. Reset works similarly to probiotics, delivering more than 5 billion active probiotic cells supporting vaginal health GYNECOLOGIST RECOMMENDED: With our patented Bio-Match technology, our products closely mimic your natural chemistry. Whether a lubricant, a wash, a moisturizer or suppository, they Work The Way You Do so that you can live, feel, and love your very best PACKAGING MAY VARY: New look, new name, but same great product and quality care! Shoppers of BiopHresh can now find the item theyve loved with the Reset name See more product details,ACCESSIBLE OVER-THE -COUNTER RELIEF: The first vaginal suppository of its kind, Reset provides affordable and easily accessible relief and bacterial vaginosis treatment. Helps relieve itching, irritation, vaginal odors, and abnormal discharge,WORKS WHILE YOU SLEEP: Each Reset capsule is inserted vaginally rather than swallowed, dissolves easily, and works while you sleep. Regular use of Reset, along with good hygiene, helps you maintain vaginal health and find relief from BV symptoms,EASY TO USE FEMININE CARE: Each pack contains 10 suppository gel capsules and a reusable, easy-to-clean applicator. Use every 3 days for up to 7 days, or as instructed by a doctor, to help reduce BV symptoms. Reset helps promote urinary tract health,HELPS MAINTAIN VAGINAL HEALTH: A healthy vaginal biome has a low pH and a proper balance of moisture, salt, and lactic acid. Reset works similarly to probiotics, delivering more than 5 billion active probiotic cells supporting vaginal health,GYNECOLOGIST RECOMMENDED: With our patented Bio-Match technology, our products closely mimic your natural chemistry. Whether a lubricant, a wash, a moisturizer or suppository, they Work The Way You Do so that you can live, feel, and love your very best,PACKAGING MAY VARY: New look, new name, but same great product and quality care! Shoppers of BiopHresh can now find the item theyve loved with the Reset name